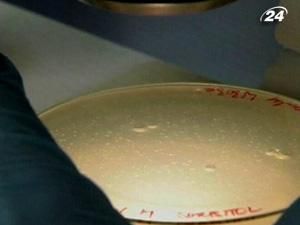
Американські вчені вперше у світі синтезували штучну клітину Американські вчені вперше у світі синтезували штучну клітину

Нову клітину охрестили "Сінтією". Вчені вважають, що цей мікроорганізм принесе велику користь людству.
Крейг Вентер (керівник проекту, засновник Інституту Крейга Вентера): “Це потужний інструмент для вирішення важливих проблем. Зараз на планеті живе трохи менше 7 млрд. людей, але через 30-40 років нас буде 9 млрд. Вже сьогодні не вистачає їжі, чистої води, ліків, енергії, ми знищуємо планету. Уявіть, що буде згодом. Нам потрібні нові наукові інструменти. Біологія, зокрема штучна клітина, дають можливість забезпечити людство новими джерелами палива, продовольства і новими вакцинами”.
Простіше кажучи, вчені сконструювали керований організм. І тепер, переконані дослідники, вони зможуть створювати запрограмовані бактерії, які поглинатимуть вуглекислий газ, діятимуть, як антибіотики і навіть врятують світ від голоду. Втім, опоненти Вентера вважають, що він відкрив ящик Пандори.
Дженніфер Міллер (засновник і виконавчий директор Bioethics International): “Розробляючи будь-яку технологію, потрібно завжди зважувати всі за і проти. Якщо говорити конкретно про цю розробку, то треба розуміти, що вона може потрапити у руки людей зі сумнівною мораллю, до прикладу біотерористів. Ще більший ризик пов'язаний з тим, що ми не знаємо як поведуться нові організми, чи навіть нові види, коли потраплять у довкілля. Ми не знаємо як вони вплинуть на глобальну екологію і на здоров'я людини, але вчені невпинно продовжують працювати над такими розробками. Тому ми хочемо, аби дослідники завжди враховували не лише переваги, а й імовірні ризики від впровадження новітніх технологій”.
Втім, успіх експерименту радше символічний. До практичного застосування подібних технологій - створення продуктів чи палива - справа дійде не скоро, якщо взагалі дійде. Адже вчені навіть ще не до кінця зрозуміли весь процес.
Американські вчені вперше у світі синтезували штучну клітину
Дослідники синтезували штучний геном, пересадили його у бактерію і отримали повноцінний одноклітинний організм.